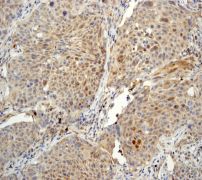

> Antigen, Antibodies, ELISA, Western Blot > Primary Antibody > Monoclonal Antibodies > PHD1 AntibodyBrand |
Leading Biology | Catalog Number |
APR09111G |
Product Type |
Monoclonal Antibodies | Field of Research |
|
Product Overview |
We constantly strive to ensure we provide our customers with the best antibodies. As a result of this work we offer this antibody in purified format.
We are in the process of updating our datasheets. If you have any questions regarding this update, please feel free to contact our technical support team.
This product is a high quality PHD1 antibody.
|
||
Molecular Weight |
43650 Da
|
||
Cellular Localization |
Antigen Cellular Localization:
Nucleus
|
||
Host |
Rabbit
|
||
Species Reactivity |
Human, Mouse, Rat
|
||
Target |
A synthetic peptide corresponding to residues in human PHD1 was used as an immunogen.
|
||
Clone |
EPR2746
|
||
Symbol |
EIT6
|
||
GeneID |
|||
UniProt ID |
|||
Function |
Cellular oxygen sensor that catalyzes, under normoxic conditions, the post-translational formation of 4-hydroxyproline in hypoxia-inducible factor (HIF) alpha proteins. Hydroxylates a specific proline found in each of the oxygen-dependent degradation (ODD) domains (N-terminal, NODD, and C-terminal, CODD) of HIF1A. Also hydroxylates HIF2A. Has a preference for the CODD site for both HIF1A and HIF2A. Hydroxylated HIFs are then targeted for proteasomal degradation via the von Hippel-Lindau ubiquitination complex. Under hypoxic conditions, the hydroxylation reaction is attenuated allowing HIFs to escape degradation resulting in their translocation to the nucleus, heterodimerization with HIF1B, and increased expression of hypoxy-inducible genes. EGLN2 is involved in regulating hypoxia tolerance and apoptosis in cardiac and skeletal muscle. Also regulates susceptibility to normoxic oxidative neuronal death. Links oxygen sensing to cell cycle and primary cilia formation by hydroxylating the critical centrosome component CEP192 which promotes its ubiquitination and subsequent proteasomal degradation. Hydroxylates IKBKB, mediating NF-kappaB activation in hypoxic conditions. Target proteins are preferencially recognized via a LXXLAP motif.
|
||
Summary |
Prolyl hydroxylase domain-containing protein 1 (PHD1, Hypoxia-inducible factor prolyl hydroxylase 1) is a 2-oxoglutarate and dioxygen-dependent enzyme that mediates the rapid destruction of hypoxia-inducible factor (HIF) alpha subunits (1) by catalyzing their post-translational formation. PHD1 functions as a cellular oxygen sensor and, under normoxic conditions, targets HIF through the hydroxylation for proteasomal degradation via the von Hippel-Lindau ubiquitination complex. It is also suggested to play a role in cell growth regulation (2). Loss of PHD1 has been shown to lower oxygen consumption in skeletal muscle by reprogramming glucose metabolism from oxidative to more anaerobic ATP production through activation of a Pparalpha pathway (3). Studies in a wide variety of cell lines revealed a predominant species at the predicted molecular mass (44 kDa) and an additional species running at a slightly increased mobility (40 kDa) (4).
|
||
Form |
50 mM Tris-Glycine (pH 7.4), 0.15 M NaCl, 40% Glycerol, 0.01% sodium azide and 0.05% BSA. |
||
Storage & Stability |
Store at +4°C short term. For long-term storage, aliquot and store at -20°C or below. Stable for 12 months at -20°C. Avoid repeated freeze-thaw cycles.
|
||
Applications |
WB, IHC
|
||
Dilution |
WB~~1:1000
IHC~~1:100~250
|
||
Synonyms |
Egl nine homolog 2, Estrogen-induced tag 6, HPH-3, Hypoxia-inducible factor prolyl hydroxylase 1, HIF-PH1, HIF-prolyl hydroxylase 1, HPH-1, Prolyl hydroxylase domain-containing protein 1, PHD1, EGLN2, EIT6
|
||
Images |

Western blot analysis on (A) A549, (B) HeLa and (C) MCF-7 cell lysates using anti-PHD1 RabMAb (Cat. APR09111G). 
Immunohistochemical analysis of paraffin-embedded human breast carcinoma tissue using anti-PHD1 RabMAb (Cat. APR09111G).
Immunohistochemical analysis of paraffin-embedded human lung carcinoma tissue using anti-PHD1 RabMAb (Cat. APR09111G). |
||
Specification |
|||
Quantity |
|
||
| Select | Brand | Catalog No. | Product Name | Pack Size | Type | Field of Research | Specification | Quantity | Price(USD) | |
| 1 | Leading Biology | APG02467G | CCK4 / PTK7 Antibody (clone 4F9) | 50 μl | Monoclonal Antibodies |
|
$495.00 | Add Ask | ||
| 2 | Leading Biology | AMM04683G | GALT Antibody (clone 4C11) | 50 μg | Monoclonal Antibodies |
|
$545.00 | Add Ask | ||
| 3 | Leading Biology | AMM01402G | Vimentin (Mesenchymal Cell Marker) Antibody - With BSA and Azide | 50 ug | Monoclonal Antibodies |
|
$395.00 | Add Ask | ||
| 4 | Leading Biology | APR08280G | LTA4H / LTA4 Antibody (clone 9G8) | 50 μl | Monoclonal Antibodies |
|
$495.00 | Add Ask | ||
| 5 | Leading Biology | AMM00172G | CD1a / HTA1 (Mature Langerhans Cells Marker) Antibody - With BSA and Azide | 50 ug | Monoclonal Antibodies |
|
$395.00 | Add Ask | ||
| 6 | Leading Biology | AMM05750G | CEBPA Antibody | 100 μl | Monoclonal Antibodies |
|
$545.00 | Add Ask |
 Leading Biology Inc.
2600 Hilltop DR, Building G, B Suite C138
Richmond, CA, 94806
Tel: 1-661-524(LBI)-0262
Email: info@leadingbiology.com
Leading Biology Inc.
2600 Hilltop DR, Building G, B Suite C138
Richmond, CA, 94806
Tel: 1-661-524(LBI)-0262
Email: info@leadingbiology.com
Complete this form and click send to ask us a question, request a quote or simply say hello.

You have 0 item in your cart

You have 0 item in your inquiry list
